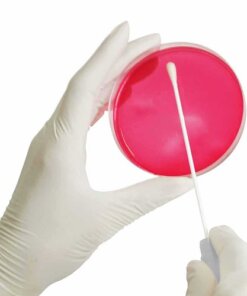

Swab P/ Coleta e Transporte Com Meio Suart Estéril – K41-0102 – OLEN
Aplicação:
O Swab para Coleta e Transporte com meio Stuart é essencial para a obtenção de diagnósticos precisos em ensaios clínicos. Este produto oferece segurança durante as etapas de coleta, armazenamento e transporte de amostras. O Swab para Coleta com meio de Transporte apresenta três funcionalidades diferentes:
Coleta de amostras através de sua ponta estéril;
Armazenamento em tubo com vedação;
Transporte em tubo semipreenchido com o meio de transporte adequado.
Os meios de transporte que preenchem os tubos fornecem proteção contra diferentes microrganismos, facilitando os procedimentos laboratoriais e aumentando o desempenho dos ensaios.
Características:
Swab com sistema coletor de amostra e transporte;
Coletor anexado à tampa do tubo;
Tubo fabricado em polipropileno;
Tampa com alta vedação, evitando a perda de amostra e contaminações;
Etiqueta para identificação da amostra colada no tubo;
Dimensões do tubo: 13 x 150 mm.
Registro na ANVISA: 80884880003
Apresentação: 100 unidades por caixa.
Modelo: K41-0102 – Marca: Olen
Imagens meramente ilustrativas.